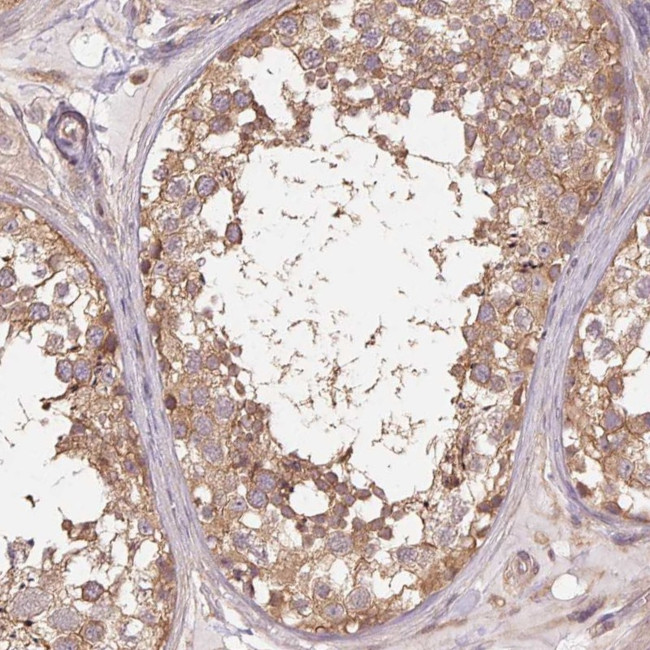
Tubulin alpha-1B Antibody in Immunohistochemistry (Paraffin) (IHC (P))

Search
Invitrogen
Tubulin alpha-1B Polyclonal Antibody
{{$productOrderCtrl.translations['antibody.pdp.commerceCard.promotion.promotions']}}
{{$productOrderCtrl.translations['antibody.pdp.commerceCard.promotion.viewpromo']}}
{{$productOrderCtrl.translations['antibody.pdp.commerceCard.promotion.promocode']}}: {{promo.promoCode}} {{promo.promoTitle}} {{promo.promoDescription}}. {{$productOrderCtrl.translations['antibody.pdp.commerceCard.promotion.learnmore']}}

Please note: We are reviewing Western blot images included in the antibody testing data in our catalog, including those provided by third parties. Unless expressly labeled or annotated as “raw-unedited”, Western blot images included in the antibody testing data in our catalog may have been edited, optimized or otherwise adjusted for presentation.
产品信息
PA5-84595
种属反应
宿主/亚型
分类
类型
抗原
偶联物
形式
浓度
规格
纯化类型
保存液
内含物
保存条件
运输条件
RRID
产品详细信息
Immunogen sequence: NTTAIAEAWA RLDHKFDLMY AKRAFVHWY
Highest antigen sequence indentity to the following orthologs: Rat - 100%, Mouse - 100%.
靶标信息
The microtubules are intracellular dynamic polymers made up of evolutionarily conserved polymorphic alpha/beta-tubulin heterodimers and a large number of microtubule-associated proteins (MAPs). Microtubules have their intrinsic polarity; highly dynamic plus ends and less dynamic minus ends. Microtubules are required for vital processes in eukaryotic cells including mitosis, meiosis, maintenance of cell shape and intracellular transport. Microtubules are also necessary for movement of cells by means of flagella and cilia. In mammalian tissue culture cells microtubules have their minus ends anchored in microtubule organizing centers (MTOCs).The GTP (guanosintriphosphate) molecule is an essential for tubulin heterodimer to associate with other heterodimers to form microtubule. In vivo, microtubule dynamics vary considerably. Microtubule polymerization is reversible and a populations of microtubules in cells are on their minus ends either growing or shortening - this phenomenon is called dynamic instability of microtubules. The alpha-tubulin (relative molecular weight around 50 kDa) is globular protein that exists in cells as part of soluble alpha/beta-tubulin dimer or it is polymerized into microtubules. In different species it is coded by multiple tubulin genes that form tubulin classes (in human 6 genes).
仅用于科研。不用于诊断过程。未经明确授权不得转售。
篇参考文献 (0)
生物信息学
蛋白别名: Alpha-tubulin ubiquitous; Tubulin alpha-1B chain; Tubulin alpha-ubiquitous chain; Tubulin K-alpha-1
基因别名: TUBA1B
Entrez Gene ID: (Human) 10376